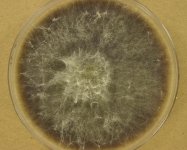

Search Details
| UAMH Number: | 11670 |
|---|---|
| Species Name: | Chaetomium sp. |
| Type: | |
| Synonyms: | Bolacotricha / Chaetomiotricha / Cladochaete / Vanhallia |
| Taxonomy: | FUNGI Ascomycota, Sordariomycetes, Sordariales, Chaetomiaceae |
| Strain History: | Dynalife Diagnostic Lab Services (68152) -> UAMH |
| Substrate: | vitreous fluid, left eye in patient with multiple brain abscesses, sudden loss of vision and history of chronic sinusitis | Location: | CANADA Alberta, Edmonton (GEO: 53.544,-113.491) |
| Isolator: | |
| Isolation Date: | 2012-11-06 |
| Date Received: | 2012-11-13 |
| Characters: | CULTURE CONDITIONS grows better @ 30C than @ 35C - fide UAMH 2012 // CULTURE CONDITIONS Phialidic conidia in chains and infertile ascomata with straight hairs produced - // MOLECULAR SYSTEMATICS Blast match 99-100% ITS similarity with Chaetomium species - fide UAMH 2012 // MOLECULAR SYSTEMATICS Close to Chaetomium globosum but cultural features suggest possible affinity to heterothallic Chaetomium subaffine - (Click for publications citing UAMH 11670) |
| Compounds: | |
| Cross Reference: | MY10236 |
| Collections: | Living Strains; Dried Herbarium Material |
| Pathogenic Potential: | Human: yes | Animal: no | Plant: no |
| Biosafety Risk Group: | RG2 (check the PHAC ePATHogen Risk Group Database for updates) |
| Regulatory Requirements: | Canadian requesters must provide PHAC Pathogen and Toxin License Number (see: https://www.canada.ca/en/public-health/services/laboratory-biosafety-biosecurity/licensing-program.html) prior to shipment. International requesters must provide all legally required importation documentation prior to shipment. Plant pathogenicity status may be verified by using the USDA Agricultural Research Service (ARS) Fungal Database |
| MycoBank ID: | 953 |
| Sequences: | >UAMH11670_UAMH_D1D2 TGNCCTAGTAACGGCGAGTGAAGCGGCAACAGCTCAAATTTGAAATCTGGCTTCGGCCCGAGTTGTAATTTGCAGAGGAAGCTTTAGGCGCGGCACTTTCTGAGTCCCCTGGAACGGGGCGCCATAGAGGGTGAGAGCCCCGTATAGTTAGATGCCTAGCCTGTGTAAAGCTCCTTCGACGAGTCGAGTAGTTTGGGAATGCTGCTCAAAATGGGAGGTAAATTTCTTCTAAAGCTAAATACCGGCCAGAGACCGATAGCGCACAAGTAGAGTGATCGAAAGATGAAAAGCACTTTGAAAAGAGGGTTAAATAGCACGTGAAATTGTTGAAAGGGAAGCGCTTGTGACCAGACTTGCGCCGGGCAGATCATCCGGTGTTCTCACCGGTGCACTCTGCCCGGCTCAGGCCAGCATCGGTTCTCGCGGGGGGATAAAGGCCCTGGGAACGTAGCTCCTCCGGGAGTGTTATAGCCCGGGGCGTAATGCCCTCGCGGGGACCGAGGTTCGCGCATCTGCAAGGATGCTGGCGTAATGGTCATCAGCGACCCGTCTTGAAACACGGACCAAGGAGTCAAGGTTTTGCGCGAGTGTTTGGGTGTAAAACCCGCACGCGTAATGAAAGTGAACGTAGGTGAGAGCTTCGGCGCATCATCGACCGATCCTGATGTTT >UAMH11670_UAMH_ITS CATTACAGAGTTGCAAAACTCCCTACACCATTGTGAACGTTACCTAAACCGTTGCTTCGGCGGGCGGCCCCGGGGTTTACCCCCCGGGCGCCCCTGGGCCCCACCGCGGGCGCCCGCCGGAGGTCACCAAACTCTTGATAATTTATGGCCTCTCTGAGTCTTCTGTACTGAATAAGTCAAAACTTTCAACAACGGATCTCTTGGTTCTGGCATCGATGAAGAACGCAGCGAAATGCGATAAGTAATGTGAATTGCAGAATTCAGTGAATCATCGAATCTTTGAACGCACATTGCGCCCGCCAGTATTCTGGCGGGCATGCCTGTTCGAGCGTCATTTCAACCATCAAGCCCCGGGCTTGTGTTGGGGACCTGCGGCTGCCGCAGGCCCTGAAAAGCAGTGGCGGGCTCGCTGTCACACCGAGCGTAGTAGCATACATCTCGCTCTGGGCGTGCTGCGGGTTCCGGCCGTTAAACCCCCTTTAACCCAAGGTTGACCTCGGATCAGGTAGGAAGACCCGCTGAACTTAAGCATATCAATAAGCGGAGGAAAAGAAACCAACAG >UAMH11670_UAMH_LSU CCTAGTAACGGCGAGTGAAGCGGCAACAGCTCAAATTTGAAATCTGGCTTCGGCCCGAGTTGTAATTTGCAGAGGAAGCTTTAGGCGCGGCACTTTCTGAGTCCCCTGGAACGGGGCGCCATAGAGGGTGAGAGCCCCGTATAGTTAGATGCCTAGCCTGTGTAAAGCTCCTTCGACGAGTCGAGTAGTTTGGGAATGCTGCTCAAAATGGGAGGTAAATTTCTTCTAAAGCTAAATACCGGCCAGAGACCGATAGCGCACAAGTAGAGTGATCGAAAGATGAAAAGCACTTTGAAAAGAGGGTTAAATAGCACGTGAAATTGTTGAAAGGGAAGCGCTTGTGACCAGACTTGCGCCGGGCAGATCATCCGGTGTTCTCACCGGTGCACTCTGCCCGGCTCAGGCCAGCATCGGTTCTCGCGGGGGGATAAAGGCCCTGGGAACGTAGCTCCTCCGGGAGTGTTATAGCCCGGGGCGTAATGCCCTCGCGGGGACCGAGGTTCGCGCATCTGCAAGGATGCTGGCGTAATGGTCATCAGCGACCCGTCTTGAAACACGGACCAAGGAGTCAAGGTTTTGCGCGAGTGTTTGGGTGTAAAACCCGCACGCGTAATGAAAGTGAACGTAGGTGAGAGCTTCGGCGCATCATCGACCGATCCTGATGTTTTCGGATGGATTTGAGTAGGAGCGTTAAGCCTTGGACCCGAAAGATGGTGAACTATGCTTGGATAGGGTGAAGCCAGAGGAAACTCTGGTGGAGGCTCGCAGCGGTTCTGACGTGCAAATCGATCGTCAAATCTGAGCATGGGGGCGAAAGACTAATCGAACCATCTAGTAGCTGGTTACCGCCGAAGTTTCCCTCAGGATAGCAGTGTTGTCTTCAGTTTTATGAGGTAAAGCGAATGATTAGGGACTCGGGGGCGCTTTTTAGCCTTCATCCATTCTCAAACTTTAAATATGTAAGAAGCCCTTGTTACTTAATTGAACGTGGGCATTCGAATGTACCAACACTAGTGGGCCATTTTTGGTAAGCAGAACTGGCGATGCGGGATGAACCGAACGCGGGGTTAAGGTGCCGGAGTGGACGCTCATCAGACACCACAAAAGGCGTTAGTACATCTTGACAGCAGGACGGTGGCCATGGAAGTCGGAATCCGCTAAGGACTGTGTAACAACTCACCTGCCGAATGTACTAGCCCTGAAAATGGATGGCGCTCAAGCGTCCCACCCATACCCCGCCCTCAGGGTAGAAACGATGCCCTGA |
IMAGES: